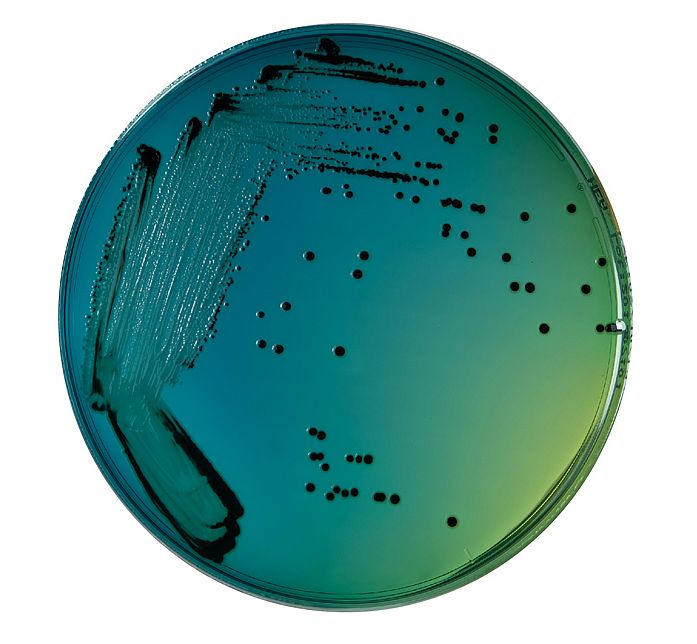

Artykuły

Adenowiroza - tajemnicza choroba wirusowa młodych gołębi budząca postrach wśród hodowców
Adenowiroza - choroba młodych gołębi
Adenowiroza, to ostatnio bardzo duży problem w hodowlach gołębi pocztowych i ozdobnych. Choroba ta budzi postrach wśród hodowców i coraz częściej jest przyczyną dużych strat młodych gołębi. Adenowirusy, to małe dwudziestościenne bezotoczkowe wirusy wielkości 74-90nm. Zawierają dwuniciowy DNA oraz 252 podjednostki strukturalne zwane kapsomerami. Namnażają się one w jądrach zakażonych... Szczegóły

Publikacje dla hodowców gołębi pocztowych...
W Polsce mamy bardzo niewiele publikacji o gołębiach pocztowych. Przykrym jest stwierdzić, ze nie jest wydawany w formie drukowanej żaden periodyk poświęcony gołębiom pocztowym i sportowi gołębiarskiemu, a szkoda. Jeszcze na początku naszego wieku na rynku obecnych było kilka miesięczników: "Dobry Lot", "Hodowca Gołębi Pocztowych", "Złoty Gołąb" oraz okresowo jeszcze kilka innych np. "Mistrzowskie Hodowle" czy "Gołąb Pocztowy". Niestety prasa tradycyjna została... Szczegóły

Polska Liga Gołębi Pocztowych
Polska Liga Gołębi Pocztowych obejmuje kilka gołębników, których wyniki lotowe gromadzimy w jednym miejscu i je porównujemy. Mamy więc gołębie w ramach naszej ligi zarówno na południu jak i na północy Polski ale też i na Słowacji. Gdzie są te gołębniki możemy zobaczyć na zamieszczonej na naszej stronie liście. W ciągu ostatnich kilku lat wiele z tych gołębi reprezentowało PLGP i hodowców,... Szczegóły

Nasza misja
Podstawowym celem dzialaności naszej fundacji jest propagowanie i promocja hodowli gołębi pocztowych i sportu gołębiarskiego. Hodowla gołębi pocztowych i organizowanie lotów tych ptaków kilka lat temu zostały wpisane na listę dziedzictwa kulturowego w Polsce. Pasja ta przyciąga wiele osób jednak aby ona nie zaginęła ciągle trzeba ją rozwijać i propagować. Niestety ostatnimi czasy obserwujemy spadek zainteresowania tą działalnością. Nie jest to... Szczegóły

Bajkowy Bohater i gołębie pocztowe
Hodowla gołębi pocztowych to pasja, którą ma się do końca życia. Kiedy jako dzieci stykamy się z kimś kto hoduje gołębie pocztowe mamy tylko dwie drogi. Albo zarazimy się tym hobby albo będziemy obojętni czy też wręcz będziemy ich nie cierpieć. Wielu zniechęca się do gołębi z powodów całkowicie racjonalnych. Trzeba codziennie poświęcać im wiele czasu. Musimy je karmić, poić, sprzątać gołębniki, dbać o kondycję i zdrowie... Szczegóły